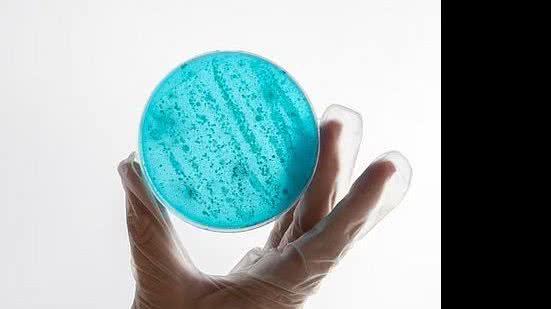
Freepik

A cada ano, cerca de 7,7 milhões de pessoas morrem por causas atribuídas a infecções bacterianas. Dessas, 1,27 milhões são associadas a bactérias resistentes a antibióticos. Um novo estudo, porém, mostra que medidas como vacinaç&a...
A cada ano, cerca de 7,7 milhões de pessoas morrem por causas atribuídas a infecções bacterianas. Dessas, 1,27 milhões são associadas a bactérias resistentes a antibióticos.
Um novo estudo, porém, mostra que medidas como vacinação e acesso a saneamento básico podem reduzir cerca de 750 mil destas mortes.
A estimativa faz parte de um levantamento divulgado nesta quinta (23) na revista científica The Lancet, a mais renomada do meio médico.
LEIA TAMBÉM
O número chama atenção para os casos de bactérias resistentes a antibióticos, problema presente em todo mundo, mas que afeta particularmente a parcela mais pobre dos países.
Ana Cristina Gales, professora da Escola Paulista de Medicina da Unifesp (Universidade Federal de São Paulo) e uma das autoras da série de estudos, explica que existem medidas relativamente simples que podem ser implementadas nos países para reduzir essas mortes.
Uma delas é a vacinação contra outros agentes infecciosos, que podem prevenir hospitalizações e impedir o prolongamento hospitalar --este, sim, associado a infecções bacterianas.
"Você vai ter uma pneumonia bacteriana como uma complicação da gripe e vai usar antibiótico. Então, se você se vacinar contra a gripe, a chance de ter gripe é menor e, consequentemente, terá menos pneumonias bacterianas como complicação desses casos e usará menos antibiótico", explica.
As bactérias resistentes impactam milhares de pessoas. Embora todos estejam sujeitos a essas complicações, crianças, idosos e imunocomprometidos são os principais afetados. Nestes grupos, vacinação contra doenças respiratórias, como a gripe, causada pelo vírus influenza, e contra bactérias pneumocócicas, podem ser aliadas no combate a infecções.
Saneamento básico e acesso à água potável são outras ações que poderiam diminuir a mortalidade por bactérias resistentes: mais especificamente ao evitar cerca de 247 mil mortes por ano, de acordo com as estimativas do estudo. De forma parecida, melhor higienização de equipamentos utilizados em hospitais e UTIs (Unidades de Terapia Intensiva), por exemplo, pode impedir 337 mil óbitos por essa causa.
Uma das razões da pesquisa ser publicada agora é que o tema será discutido na Assembleia-Geral da ONU (Organização das Nações Unidas), em setembro. "A gente queria ver qual tinha sido o progresso e o que precisava ser feito em relação à resistência bacteriana", afirma Gales, que é também vice-coordenadora do Aries (Antimicrobial Research Institute of São Paulo), um centro de Pesquisa, Inovação e Difusão(Cepid) financiado pela Fapesp (Fundação de Amparo à Pesquisa do Estado de São Paulo).
Países mais ricos já adotam medidas importantes para combater essas doenças. O cenário, no entanto, é diferente nos locais mais pobres, que também são as regiões com os piores índices de mortalidade associada a bactérias resistentes. Na África Subsaariana, por exemplo, a incidência é de 98 mortes a cada 100 mil habitantes, enquanto em países ricos esse número é 55 óbitos a cada 100 mil habitantes.
Por essa razão, a pesquisadora defende um acordo internacional. No caso do Brasil, o país conseguiu progredir nos últimos anos, com sistemas de vigilância voltados para esse tipo de complicações e um plano de combate à resistência antimicrobiana.
Uma das principais causas do aparecimento de bactérias resistentes é o próprio uso de antibióticos, já que ele cria uma pressão para a manutenção do número daquelas bactérias que não são eliminadas pelos remédios. Há casos em que um paciente precisa utilizar esse tipo de medicamento -quando, por exemplo, ele conta com uma infecção bacteriana. No entanto, há situações em que o uso é inapropriado.
Por isso, a série publicada na The Lancet recomenda que, para os próximos anos, os países devem se comprometer em reduzir em 20% os casos de uso inadequado de antimicrobianos em humanos. Para animais, esse percentual deve ser de 30%.
Além disso, existe outra meta: diminuir em 10% as mortes associadas a antibióticos, algo que pode ser alcançado com a queda no uso desse tipo de medicamento e também por outras medidas, como a vacinação, saneamento básico e o diagnóstico correto.
Quando o diagnóstico é equivocado ou tardio, o cenário retarda a cura do paciente, o que aumenta o risco de mortalidade e ainda colabora com o aparecimento de bactérias resistentes.
LEIA MAIS
+Lidas